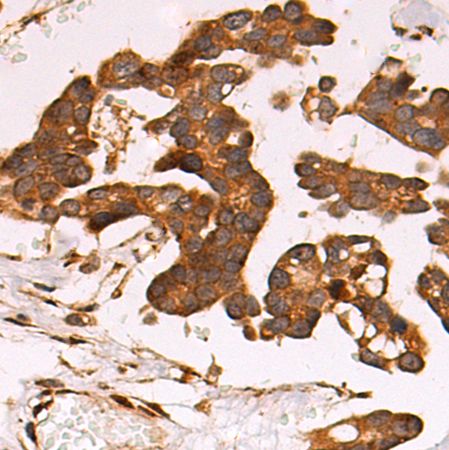
兔抗LRP1多克隆抗体

万千商家帮你免费找货
0 人在求购买到急需产品
- 详细信息
- 技术资料
- 抗体名:
兔抗LRP1多克隆抗体
- 应用范围:
仅供科研使用
- 供应商:
上海酶联生物科技有限公司
- 库存:
51
- 保质期:
1年
- 克隆性:
多克隆
- 形态:
液体
- 免疫原:
Synthetic peptide of human LRP1
- 规格:
25ul/100ul/200ul
| 规格: | 25ul | 产品价格: | ¥420.0 |
|---|---|---|---|
| 规格: | 100ul | 产品价格: | ¥1500.0 |
| 规格: | 200ul | 产品价格: | ¥2500.0 |
中文名称: 兔抗LRP1多克隆抗体
英文名称: Anti-LRP1 rabbit polyclonal antibody
别 名: LDL receptor related protein 1; APR; KPA; LRP; A2MR; CD91; APOER; LRP1A; TGFBR5; IGFBP3R; IGFBP-3R; IGFBP3R1
相关类别: 一抗
储 存: 冷冻(-20℃)
宿 主: Rabbit
抗 原: LRP1
反应种属: Human, Mouse
标 记 物: Unconjugate
克隆类型: rabbit polyclonal
酶联抗体的保存:
& 小包分批:避免多次反复冻融
& 短期保存:4℃冰箱保存
& 长期保存:-20℃,一般需要加入甘油
兔抗LRP1多克隆抗体为我司主营产品之一,产品皆严格按照相关标准进行生产,并经过了严格地反复地检测,品质保障,出库质检把控严格,公司承诺有任何质量问题包退换,诚信经营,合作共赢,我们只做行货,不用担心质量问题,售后技术支持到底!
酶联优势
& 精选原材料,批量备货,减少交易环节,经销商利润更丰厚
& 服务协调,服务监管,2小时响应
& 不抢单,不过度承诺,财务合规,承诺履约
& 畅销品牌全年不断货,24小时发货,减少资金占用,降低经营风险
& 快速响应客户需求,减少人员投入,
& 提升采购效率,拓展产品经营范围,提升业务竞争能力
& 酶联生物的技术服务人员拥有精湛的技术和丰富的经验
& 根据客户需要制定实验方案,高效、精确地助力于您完成实验,酶联生物,您不错的选择
& 高效业务流,IT系统,专业营销和技术支持
英文名称: Anti-LRP1 rabbit polyclonal antibody
别 名: LDL receptor related protein 1; APR; KPA; LRP; A2MR; CD91; APOER; LRP1A; TGFBR5; IGFBP3R; IGFBP-3R; IGFBP3R1
相关类别: 一抗
储 存: 冷冻(-20℃)
宿 主: Rabbit
抗 原: LRP1
反应种属: Human, Mouse
标 记 物: Unconjugate
克隆类型: rabbit polyclonal
酶联抗体的保存:
& 小包分批:避免多次反复冻融
& 短期保存:4℃冰箱保存
& 长期保存:-20℃,一般需要加入甘油
兔抗LRP1多克隆抗体为我司主营产品之一,产品皆严格按照相关标准进行生产,并经过了严格地反复地检测,品质保障,出库质检把控严格,公司承诺有任何质量问题包退换,诚信经营,合作共赢,我们只做行货,不用担心质量问题,售后技术支持到底!
酶联优势
& 精选原材料,批量备货,减少交易环节,经销商利润更丰厚
& 服务协调,服务监管,2小时响应
& 不抢单,不过度承诺,财务合规,承诺履约
& 畅销品牌全年不断货,24小时发货,减少资金占用,降低经营风险
& 快速响应客户需求,减少人员投入,
& 提升采购效率,拓展产品经营范围,提升业务竞争能力
& 酶联生物的技术服务人员拥有精湛的技术和丰富的经验
& 根据客户需要制定实验方案,高效、精确地助力于您完成实验,酶联生物,您不错的选择
& 高效业务流,IT系统,专业营销和技术支持
风险提示:丁香通仅作为第三方平台,为商家信息发布提供平台空间。用户咨询产品时请注意保护个人信息及财产安全,合理判断,谨慎选购商品,商家和用户对交易行为负责。对于医疗器械类产品,请先查证核实企业经营资质和医疗器械产品注册证情况。
技术资料兔抗LRP1多克隆抗体
¥420 - 2500